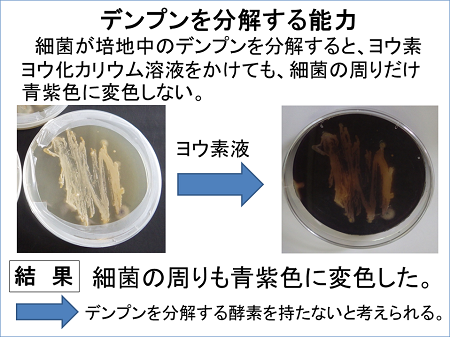
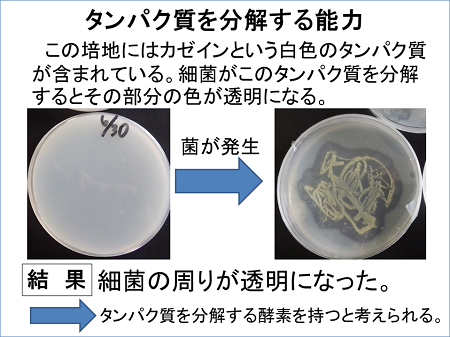

みやぎ総文2017 自然科学部門
「水素を生産する微生物」を使って、高濃度の水素を取り出そう!
【生物】千葉県立柏中央高校 科学部
(2017年8月取材)

■部員数 9人(1年生4人・2年生2人・3年生3人)
■答えてくれた人 清水拓海くん(3年)、茂呂健太くん(2年)
土壌微生物を用いたバイオ水素生産の研究
「電気分解」に頼らず「土壌中の微生物」から水素を取り出す

現在、新しいエネルギー源として注目を集めているのが水素です。水素は燃焼すると水になり、化石燃料とは違ってCO2を排出しない、クリーンエネルギーの一つです。
水素をエネルギーとする自動車も開発され、ガソリンスタンドには、水素ステーションが設置されているところもあります。
一般に、水を電気分解することで水素を得ることは可能ですが、自然界にも光合成細菌、ラン藻、クロストリジウム属、アゾトバクター属、根粒菌など水素を生産する微生物が存在しています。私たちは、土壌中に存在している「水素を発生させる微生物」を用いて、高濃度の水素を得ることができるのではないかと考え、この研究に取り組み始めました。
研究の目的は、以下の2つです。
1. 土壌から水素を生産する微生物を見つけ、発生した気体の水素濃度を測定、および発生の条件について調べる。
2. 廃棄物を用いた、バイオ水素化について検討する。
学校周辺の土から水素は発生するのか?
まず初めに、私たちは、土壌から土を採取してきて、気体が発生するかどうかを調べることにしました。土は、学校周辺にある竹やぶ、大堀川の土手、雑木林、ビオトープの4地点から採取しました。

これらの土を500mLペットボトルに200gずつ入れ、0.1%グルコース溶液を添加し、水槽に水を張って、水温を32℃に設定しました。そして、「水上置換法」で気体を発生させ、メスシリンダーに集めました。

4地点のすべてから、150mL以上の気体を得ることができました。では、実際この中に、水素は含まれているのでしょうか。

これを確認するために、3つの実験を用いました。
1. 燃焼の有無
2. 酸化銅の還元
3. 燃料電池による発電
すべての実験で、水素が含まれていることが確認できました。しかし、この時点では正確な水素濃度はまだわかっていませんでした。

自作の測定装置で水素濃度を測る
水素濃度を測るためには高価な装置を用いる必要がありますが、本校にはそのような設備はないため、私たちはその装置を自作しました。
これが自作した水素定量装置です。水素をもとに発電する「燃料電池」の電気量から、水素濃度を測定するというものです。気体注入口から発生した気体を入れ、燃料電池で発電させます。それをデジタルマルチメーターで数値化し、パソコンに毎秒ごとに自動記録していきます。

この装置に、水素濃度を100%から0%まで、25%刻みで5段階に調整した気体を流し、電気量をグラフ化しました。グラフからは正の相関が見られました。また、相関係数が0.999と強い正の相関であるため、こちらを検量線として用いることができそうです。


この検量線を用いて、4地点の水素濃度を調べてみました。どの地点も、水素が50%以上含まれていることがわかります。
このことから、水素を生産する微生物が、土壌中に存在していると考えられます。
また、それまで0.1%グルコース溶液を添加して気体の発生を試みていたのですが、添加しなくても気体が発生するという可能性を考え、実験を行ってみました。

グルコースを添加したものは水素が発生しましたが、グルコース無添加のものは、気体すら発生しませんでした。
この結果から、水素を生産する微生物から水素を得るためには、何らかの栄養源が必要であると考えられます。
水素の発生に関わる添加物は、単糖類? 二糖類? 多糖類? 廃棄物?
そこで水素を発生させるために、添加物に様々な糖類を加えて実験をすることにしました。また廃棄物でも水素が発生できないか、実験してみました。

初めに、グルコースと同じ炭水化物である単糖類や二糖類に、添加物の種類を変えて実験しました。一元分散分析した結果、グルコースの水素濃度と、その他の単糖類、二糖類の水素濃度に差異は見られませんでした。

同様に多糖類も実験を行いました。今回使用したのは、コムギデンプン、トウモロコシデンプン、ジャガイモデンプンの3種類です。単糖類や二糖類に比べ、多糖類は水素濃度が低い値となりました。
このことから、水素を生産する微生物は、こういった多糖類を分解するような酵素を持たないのではないかと考えられます。

また廃棄物に関しては今回、コーヒー豆、お茶の葉、米のとぎ汁を使用しました。結果は気体すら確認されませんでした。
水素生産微生物を単離して、その正体をつきとめる
次に水素を生産する微生物を単離し、その性状を調べました。
まず、マイクロチューブに土と水を入れてよく撹拌し、遠心分離機にかけて細菌を含む上澄み液を採取し、それを培地に移して培養しました。初めはGYP培地を用いて培養し、ここで発生した細菌の中で、グルコース培地を用いて成育できたものだけを、今回の実験で使いました。

単離した細菌だけを使って、水素が発生するかどうかを調べるための実験を行いました。
水素を発生させるための条件として、以下の3つを用意しました。
(1)細菌 (2)グルコース水溶液 (3)滅菌した土
そして、
3つすべてを合わせたもの((1)+(2)+(3))、グルコース水溶液と滅菌した土((2)+(3))、細菌とグルコース水溶液((1)+(2))の3つで、発生した気体の水素濃度を調べました。

その結果、細菌、グルコース水溶液、滅菌した土を混ぜたものからは、水素が発生しました。しかし、細菌とグルコース水溶液((1)+(2))からは、気体すら発生しませんでした。
このことから、水素を発生させるためには、土の中の、何かしらの養分が必要になるのではないかと思われます。
ここからは細菌の同定を行っていきます。まずは、その細菌が細胞壁を持つかどうかを判断するために、グラム染色を行いました。青く染まれば細胞壁を持つグラム陽性菌、赤く染まれば細胞壁を持たないグラム陰性菌です。
細菌が青く染まったことから、この細菌はグラム陽性菌という結果が出ました。また顕微鏡による観察から、この細菌は細長い形状の桿菌であることがわかりました。

本実験では、『医学細菌同定の手引き』に記載されている、グラム陽性菌の一次鑑別表に基づいて細菌の同定を試みました。

こちらが鑑別表の項目です。本校で行える実験で判別可能なものに赤い丸印をつけました。桿菌であること、空気中で発育可能であることは既に判明しているので、残りの項目について調べるために、カタラーゼ試験とヒュー・レイフソン試験を行いました。
まずはカタラーゼの有無を調べます。カタラーゼは過酸化水素と反応して、酸素を発生させる酵素です。この細菌がカタラーゼを持っている場合、過酸化水素水をかければ気体が発生します。
結果は、写真のように白い粒が発生しました。この白い粒はすべて発生した気体の気泡です。このことから、この細菌はカタラーゼを持つ細菌だと考えられます。

次にヒュー・レイフソン試験、別名O-Fテストを行いました。Oは酸化、Fは発酵という意味です。写真左のO-F培地を2つ用意し、両方に細菌を移します。片方のみ流動パラフィンを用いて酸素を遮断し、それぞれの反応を見て判別を行います。
下図の写真のように、両方の培地が黄色く変色したことから、この細菌は発酵を行う細菌だと思われます。また培地に植えた細菌が、培地の中を広がるように増えたことから、この細菌は運動性の細菌だと考えられました。


鑑別表の項目に、このように○がついていきました。この情報を元に細菌の同定を行っていきます。
『医学細菌同定の手引き』中の「グラム陽性菌の一次鑑別表」と照らし合わせると、すべての項目が一致する部分がありました。ここからある属の細菌が導き出されます。それはListeria属でした。今回の細菌は、Listeria属の細菌である可能性が出てきました。
見つかった細菌の性質をさらに詳しく調べる

Listeria属とは、食品中や土壌中に広く分泌する常在菌の一種です。しかし、この細菌が水素を生産する能力があるという文献は、確認できませんでした。
この細菌についてこれ以上調べるためには、大学や研究施設などの遺伝子を用いた調査が必要になります。

先ほど説明したように、単糖類、二糖類を用いた場合、水素は発生しましたが、デンプンを用いた場合水素濃度は低い値となりました。
そこで、単離した細菌について、デンプンやタンパク質を分解する酵素を持っているかどうかを調べるための実験を行いました。
まずはデンプンについて調べました。左の培地にはデンプンが含まれています。この細菌がデンプンを分解する酵素を持っている場合、細菌の周りのデンプンが分解され、ヨウ素ヨウ化カリウム溶液、通称ヨウ素液をかけても細菌の周りは反応せず変色しないはずだと考えました。
結果は下図の右の写真のように、培地全体が青紫色に変色しました。このことからこの細菌はデンプンを分解する酵素を持っていないと考えられます。
次に、たんぱく質について調べました。左の培地には、白色のタンパク質であるカゼインが含まれています。この細菌が、タンパク質を分解する酵素を持っていれば、細菌の周りの白色が透明になるはずです。
すると、細菌の周りの白色が透明になりました。この細菌は、タンパク質を分解する酵素を持っていると考えられます。
実用化可能なさらに高濃度の水素を得るためには…
これらの実験の結果をまとめます。
(1)土壌に0.1%グルコース水溶液を加えたところ気体が発生し、そのうち50%以上が水素でした。そのことから、土壌中に水素を生産する微生物がいるのではないかと考えられます。
(2)単糖類、二糖類を用いた場合、水素は発生しましたが、デンプンを用いた場合の水素濃度は低い値となりました。これはその細菌が、デンプンを分解する酵素を持っていないからではないかと考えました。
(3)性状試験により、Listeria属の細菌が候補として挙がりました。しかし、この細菌が水素を生産したという報告は確認できませんでした。
今後の目標は、実用化できる水素濃度95%の気体を得ることです。そのために添加物、温度、pHなどの条件を変える実験や、発生した気体から水素を分離する実験などを行っていきたいと考えています。特に、添加物に廃棄物を使えるようにしたいと考えています。
また、水素の軽さを利用して分離を試みましたが、水素濃度が最大74.9%と目標には届きませんでした。発生した気体から水素を分離するのが今後の課題です。
■研究を始めた理由・経緯は?
新しいエネルギーとして水素が注目されていること、また土壌中には水素を発生する微生物が生息することを知り、研究したいと思いました。
■今回の研究にかかった時間はどのくらい?
平日は1日あたり2時間を週5日、休日は1日あたり4時間を週1日で、合計週6日。実験は2015年の7月ごろに開始しました。
■今回の研究で苦労したことは?
細菌を培養する際に、他の細菌が入らないよう培地に移す作業が大変でした。
■「ココは工夫した!」「ココを見てほしい」という点は?
気体中の水素濃度を測るための、水素定量装置を自作したところです。
■今回の研究にあたって、参考にした本や先行研究
・浅田泰男、石見勝洋、神野英殻 (2012)バイオ水素の現状と問題点-光合成微生物を中心に-.水素エネルギーシステム.37(1):20-24
・三宅淳、若山樹(2007)微生物を用いた水素生産-水素エネルギー社会の到来に備えて-.光合成研究.17(1):6-11
・中島田豊、西尾尚道(2007) 微生物による有機資源からの発酵水素生産. 水素エネルギーシステム.32(1):16-21
・「医学細菌同定の手引き」G.I.Barrow、R.K.A.Feltham(近代出版)
■今回の研究は今後も続けていきますか?
続けていく予定です。今は、水素を含む気体から水素を分離することで、水素濃度の高い気体を得るための実験を行っています。
■ふだんの活動では何をしていますか?
生物の飼育や、学校の近くの流れる川の生物の調査などを行いながら、自分たちの興味を持った実験を行っています。
■総文祭に参加して
普段ではあまりできない経験をさせていただき、学べることが多かったです。この体験をこれからの研究の糧にしていけたらと考えます。
※柏中央高校の発表は、生物部門の最優秀賞を受賞しました。

◆みやぎ総文2017の他の発表をみる <みやぎ総文2017のページへ>
 みらいぶっくグループ
みらいぶっくグループ






